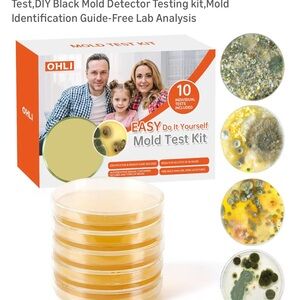
OHLI Mold Test Kit with 5 Tests

LisaB
@ls_barlow
Sort By:

$5
$99
Size: XL
Tailorbyrd
ls_barlow

$15
Size: OS
Tupperware
ls_barlow

$15
$35
Size: OS
mighty mug
ls_barlow

$8
$55
Size: L
Denim & Flower
ls_barlow

$6
$26
Size: One size
Squishmallows
ls_barlow

$10
$99
Size: 8.5
Coach and Four
ls_barlow

$8
$39
Size: OS
ls_barlow

$13
$129
Size: L
Polo Ralph Lauren
ls_barlow

Corgi plush toy
NWT
$8
$29
Size: One size
ls_barlow

$9
$39
Size: 9.5
Italian Shoemakers
ls_barlow

$40
$180
Size: S
Marmot
ls_barlow

$10
$149
Size: Neck 17.5
Joseph Abboud
ls_barlow

$38
$79
Size: OS
lululemon athletica
ls_barlow

$14
$39
Size: OS
Amazon
ls_barlow

$15
$49
Size: Xl
david Archy
ls_barlow

$15
$29
Size: OS
ls_barlow